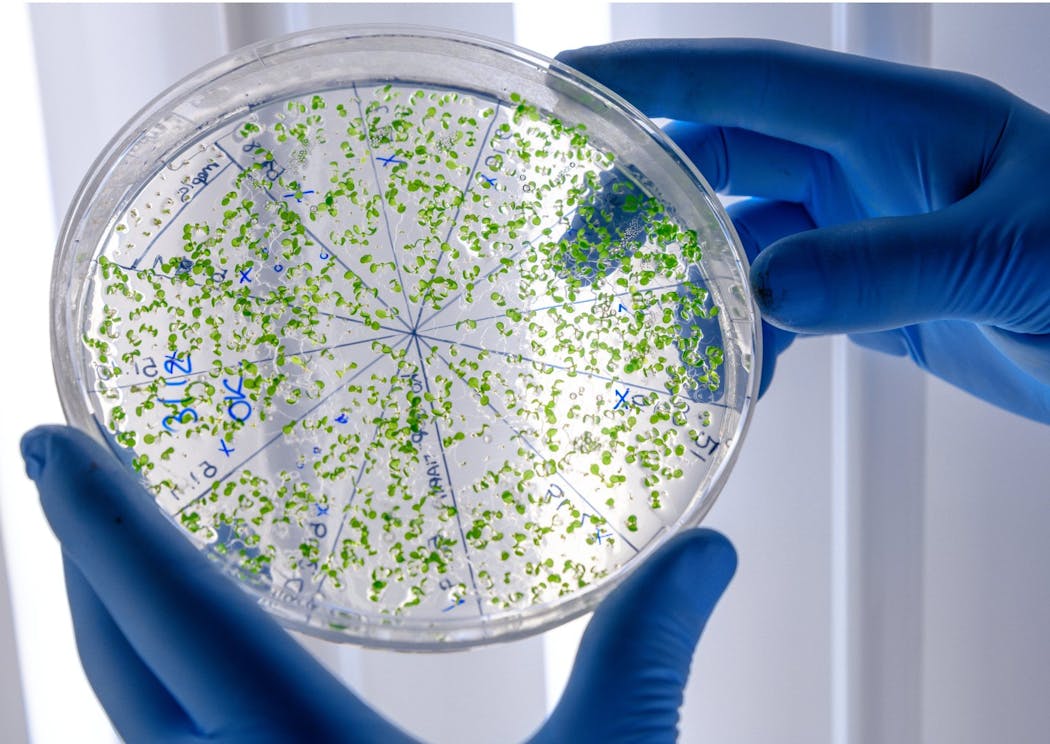
Cellule biologiche da studiare al microscopio

Biologia: Etimologia e definizione semplice in francese
Il termine “biologia” è stato creato da due parole greche: bios, “vita” e logos, “scienza”.
Che cos’è un organismo?
Organismi o organismi hanno estremi Una varietà di forme e dimensioni.
InoltreUna gambaH, potrebbero essere gli animali (meduse, topi, delfini, ecc.), Le piante (quercia, mimosa, oleandro, ecc.), Microrganismi (batteri, plancton, ecc.).
Chi è il padre fondatore della biologia?
Giovanni Battista Lamarck (1744-1829), scienziato francese vicino ai filosofi dell’Illuminismo, inventò il nome biologia per designare la scienza degli esseri viventi. Allo stesso tempo, lo scienziato tedesco Gottfried Reinhold Triverano (1776-1837) raffigura anche la parola biologia, dall’altra parte del Reno.
Treviranus e Lamarck sono considerati i padri fondatori della biologia. Nello specifico, gli scienziati che studiano la biologia sono chiamati biologi.
Qual è lo scopo della biologia?
Fin dall’inizio, i biologi Lamarck e Triveranos hanno attribuito alla biologia un duplice scopo.
Lo scopo della biologia è:
Scopri le leggi universali che rendono possibile la vita come un fatto generale
Dipingi un quadro della sua diversità e della sua storia
Biologia: l’evoluzione ad oggi
Dopo Lamarck e Triveranus, la biologia si è sviluppata molto. Oggi lì Due visioni diverse e complementari dalla biologia.
La visione rigorosa della biologia la riduce al comportamento degli organismi, sia presi isolati dal loro ambiente sia in relazione al loro ambiente.
L’ampia visione della biologia propone lo studio completo degli organismi viventi, compresi Tutte le scienze della vita. Questa è l’opinione prevalente oggi tra i biologi e il grande pubblico.
Quali sono le diverse scienze o argomenti di biologia?
Include la biologia Diverse scienze che studiano gli organismi viventi.
Ecco alcune delle principali discipline della biologia:
- Botanica: la scienza che studia le piante
- Zoologia: la scienza che studia gli animali
- Ecologia: è la scienza che studia le relazioni degli organismi viventi (animali, piante e microrganismi) con il loro ambiente, così come con altri organismi viventi
- Anatomia: è la scienza che studia la forma e la struttura degli organismi organizzati, nonché le relazioni tra i loro vari membri
- Morfologia: è la scienza che studia la forma degli esseri viventi
- Embriologia: è la scienza che studia lo sviluppo degli organismi da un uovo fecondato
- Fisiologia: la scienza che studia le funzioni e le proprietà degli organi e dei tessuti degli organismi viventi
- Genetica: la scienza che studia l’ereditarietà ei geni

“Appassionato di alcol. Piantagrane. Introverso. Studente. Amante dei social media. Ninja del web. Fan del bacon. Lettore”.